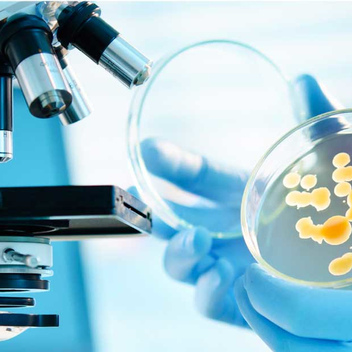
Показатели и результаты спермограммы

Бесплодие: виды, причины, диагностика

Диагностика бесплодия
Мероприятия по проведению диагностики бесплодия проводятся в условиях гинекологического отделения или поликлинике по своему месту жительства. Очень важно проводить среди населения и профилактику данного заболевания .
Необходимо сразу сказать, что бесплодие является осложнением различных заболеваний организма человека. Профилактические мероприятия должны уже проводиться с детства, чтобы закрепить данные рекомендации. В первую очередь нужно объяснить, что следует предохраняться при половых контактах. Данный вопрос особенно касается подростков. Необходимо привить понятия о половых контактах и о чистоте половых органов.
Чаще всего, около 75% бесплодий появляются вследствие различных процессов воспалительного характера. Данный процесс наблюдается в области половых органов. Сюда же входят инфекционные процессы и проникновение венерологических агентов.
Если касаться женщин, то около 80% всех женщин у которых диагностировали бесплодие, возникало вследствие абортов в раннем периоде. Частая смена половых партнеров также пагубно влияет на детородную функцию женщины. Большая вина в этом лежит родителей, которые должны были объяснить своему потомству, что необходимо соблюдать качество своей интимной жизни. Ведь иначе, в дальнейшем, репродуктивная система может пострадать из-за ошибок в молодости. Ошибкой считается беспорядочные половые связи.

Самой основной профилактикой бесплодия является своевременное лечение заболеваний репродуктивной системы. Ведь поздно выявленная патология может привести к необратимым процессам. Если произошел процесс воспаления в области слизистых тканей репродуктивных органов, то далее формируются спаечные процессы у женщины. А это прямая дорога к тому что, женщина не сможет иметь детей. Что касается мужчин, то здесь наблюдается иной процесс. Если он не лечит различные заболевания своих половых органов, то может снизиться качество и количество спермы. Сперматозоиды постепенно теряют свою подвижность. Подвижность является основной функцией сперматозоида.
Интимная жизнь играет огромную роль в детородной функции человека. Если у человека есть различные заболевания органов репродукции хронического плана, то можно предположить о дальнейшем бесплодии. Основным законом для предупреждения бесплодия является личная гигиена наружных органов репродукции, а также порядочная половая жизнь. Если постоянно происходит смена партнера, то повышается риск развития бесплодия. Данное правило касается как мужчин, так и прекрасную нашу половину.
При наличии у человека инфекционного процесса, у пациента происходит сбои микрофлоры в области половых органов. А такой процесс негативно сказывается на иммунитет, он потихоньку снижается. Далее если человек не лечит себя, то присоединяются иные патогенные агенты, что ухудшают общее состояние.
Немаловажным является такое заболевание, как анорексия. Это больше касается женской половины населения. Это патологический процесс приводит к снижению функции репродуктивной системы. Женщина не сможет нормально зачать ребенка, а уж тем более его родить. В процессе механизмов тканевого обмена, подкожно-жировая клетчатка производит синтез основного гормона. Этим представителем является эстроген. Если женщина плохо питается, то выработка этого гормона резко падает.
Итак, необходимо сделать вывод. Чтобы исключить развитие у женщины бесплодия, необходимо соблюдать элементарные правила. Такими пунктами являются:
- Исключение различных половых беспорядочных связей.
- Избегание абортов.
- Использование различных средств контрацепции.
- При появлении различных патологических процессов в области репродуктивной системы в быстрые сроки необходимо обратиться к врачу.
Также, чтобы снизить повышения риска появления бесплодия, женщина должна соблюдать чистоту своих половых органов. Кроме того, следует:
- Избегать стрессовых состояний.
- Питаться здоровой и полезной пищей.
- Исключение различных вредных привычек (табакокурение, алкоголь, наркотические средства).
- Постоянный контроль врача, по поводу половой системы (профосмотры).
Если выполнять вышеуказанные рекомендации, то можно избежать страшного приговора – бесплодие.
Диагностика женского бесплодия
Чтобы провести диагностические мероприятия по женскому бесплодию, необходимо знать, какие существуют разновидности данного патологического состояния. Ни в коем случае нельзя проводить лечебные мероприятия, без предварительной диагностики. Иначе можно просто навредить женщине, у которой и так уже есть проблемы с репродуктивной системой. Чаще всего для проведения диагностических мероприятий, для женщины назначается исследование ультразвуковым аппаратом. Кроме того, сдают определенные анализы, которые назначает лечащий врач. Как только выясняется определенная картина по данному заболеванию, то можно приступать к лечебным мероприятиям. Бесплодие является неблагоприятным заболеванием. В некоторых случаях можно помочь женщине и вылечить бесплодие, а в других случаях невозможно. Но не стоит унывать женщине, ведь существует альтернативный способ зачатия и рождения ребенка. Таким способом является экстракорпоральное оплодотворение.

Диагностика предусматривает выявление разновидности бесплодия. Существуют различные виды бесплодия у женщин. Такой диагноз ставится тогда, когда пара не может зачать ребенка в течение одного года. Регулярная интимная связь присутствует, а зачатие не происходит. Регулярность половой жизни считается тогда, когда интимный контакт происходит не реже одного раза за семь дней. При этом супружеская пара не должна предохраняться, то есть не использовать средства защиты.
Учитывая статистические данные, то родить пара не может из-за различных проблем у мужчин – 42% случаев. Такая же цифра наблюдается тогда, когда у женщин есть проблемы с репродуктивной системой. Около 15% пар являются одновременно бесплодными. То есть наблюдается дисфункция половых органов у обоих партнеров. Если происходят патологические процессы в организме, в частности в репродуктивной системе, то в дальнейшем это может негативно отразится при зачатии ребенка.
Если коснуться бесплодия мужского происхождения, то он чаще всего возникает в результате определенных причин. Таковыми причинами являются:
- Процессы воспалительного характера.
- Наличие инфекционного агента.
- Частичная или полная непроходимость канала, для выноса семени.
- Увеличение вен яичка, то есть варикозное расширение.
- Нарушения гормонального плана.
- Расстройства сексуального плана, на уровне психики мужчины.
- Резкое падение потенции.
Данные причины необходимо знать, чтобы проводить дифференциальную диагностику с бесплодием у женщины.
Виды бесплодия у женщины определяются тогда, когда определены причины патологического состояния. Чаще всего невозможность родить ребенка у женщины наблюдается тогда, когда у нее есть процессы воспалительного характера органов репродукции. Инфекционные процессы, нарушения гормонального плана, закупоривание труб матки, врожденные дефекты матки, а также разрастание эндометрия – часто встречающиеся причины бесплодия.
По своей разновидности, бесплодность у лиц женского пола бывает:
- Относительным, когда родить ребенка есть шансы, но они довольно низкие.
- Абсолютным. Это тот самый случай, когда ни при каких обстоятельствах женщина не в состоянии родить ребенка на свет. Существуют определенные заболевания, которые способствуют к такому процессу.

Абсолютное бесплодие бывает не только у женщин, но и у мужчин. В практической части, есть факторы, когда можно говорить о полном бесплодии. Такими факторами являются:
- Отсутствие репродуктивных клеток мужчины (сперматозоиды) и у женщины яйцеклеток.
- Отсутствие некоторых органов репродукции. Это матка, яичник и маточная труба.
По своему делению, существуют такие разновидности бесплодия у женщины:
- Первичное.
- Вторичное.
Если женщина никогда не рожала и у нее диагностировано бесплодие, то можно сказать, что у нее патология первичного характера.
Естественно, вторичное бесплодие — это тогда, когда она уже хоть раз была беременна. При этом не имеет значение, родила она ребенка, произошел выкидыш, беременность внематочной локализации или аборт.
Следует отметить, что бесплодие первичного и вторичного характера присуще не только женщине, но и мужчине. Если спросите, как определить, то это не проблематично. Первичное бесплодие у мужчины бывает тогда, когда от него ни разу какая-либо партнерша не смогла забеременеть. Вторичное мужское бесплодие наблюдается тогда, когда ранее у партнера родился ребенок от него, но далее все попытки оплодотворить свою спутницу были безуспешны.
Также бесплодие разделяется по половой принадлежности:
- Женское.
- Мужское.
- Комбинированное.
Наблюдались такие случаи, когда не сразу удавалось определить, кто из партнеров не может иметь ребенка. Поэтому следует проводить диагностические мероприятия для обоих партнеров.
Бесплодие женского генеза разделяются также по этиологической принадлежности. Среди них:
- Бесплодие трубной локализации.
- Перитонеальное и трубное бесплодие (комбинированное).
- Бесплодие эндокринного происхождения.
- Эндометриальное бесплодие.
Стоит отметить, о таком типе бесплодия, как идиопатическое. Данная разновидность встречается довольно редко. Многие врачи разводят руками, и не могут выяснить, почему женщина не может забеременеть. Есть гипотеза, что такое бесплодие появляется тогда, когда есть нарушения психоэмоционального плана.

Существует такой тип бесплодия, как ложный. Есть его некоторые варианты, которые распространены среди женщин. Таковыми являются:
- Пациентка очень большой промежуток времени лечится от бесплодия, при этом используется куча лекарственных средств. Но она абсолютно не живет интимной жизнью, так как нет полового спутника.
- Женщина длительное время лечится от бесплодия, в некоторых случаях 2-3 года. Но в результате оказывается такая причина, когда после каждого полового акта она проводит спринцевание своего влагалища.
Диагностика мужского бесплодия
Диагностика бесплодия у мужчины проводится для того, чтобы выяснить причину возникновения недуга, а также для проведения дальнейшего лечения. Существуют основные критерии, которые необходимо соблюдать, чтобы полноценно провести мероприятия диагностического плана. Таковыми являются:
- Врач проводит осмотр пациента. То есть изучаются гениталии мужчины, их общее состояние.
- Далее изучается анамнез мужчины. То есть доктор расспрашивает больного. Были ли ранее различные оперативные вмешательства, травмы, или иные патологические процессы в области репродуктивной системы. Не помешает врачу узнать у мужчины различные привычки полового характера.
- Проведение спермограммы. То есть у мужчины забирается сперма, которая потом используются для ее изучения в лабораторных условиях. Изучается как количественный, так и качественный состав данной семенной жидкости. Данное обследование дает возможность оценить жизненные возможности мужских половых клеток. Могут ли они вообще выполнять свою основную функцию – оплодотворить яйцеклетку.
- Изучение в организме мужчины различных процессов инфекционного плана. Необходимо выяснить процессы воспаления в системе репродукции.
В конце концов, если все обследования показали норму, то необходимо искать причину не у мужчины, а у супруги. Ведь бесплодие сразу невозможно выявить, часто бывает ошибочным, когда бесплодие ставят тому, или иному человеку.

Если вышеуказанных обследований недостаточно, то лечащий врач назначает дополнительные методы исследования, чтобы поставить окончательную точку в данном вопросе.
Что касается дополнительных методик, то они иногда решают вопрос в диагностике бесплодия. Таковыми являются:
- Исследование мошонки аппаратом ультразвукового плана. Данная методика дает возможность оценить деятельность этого органа, часто можно выявить варикоцеле, процессы воспаления яичка, или иных процессов патологического плана.
- Изучение крови мужчины на наличие уровня гормонов в организме. Если выявлен переизбыток, или недостаток, то необходимо срочно бить тревогу и решать данный вопрос. Самым основным гормоном у мужчины является тестостерон. Именно он отвечает, как за половое развитие мужчины, так и за выработку мужских половых клеток, их деятельность и основную функцию.
- Взятие мочи для проведения лабораторного исследования. При этом нужно собирать мочу после того, как была эякуляция спермой. Если в самой моче будут выявлены следы спермы, то можно говорить, что у мужчины ретроградное выделение спермы в полости мочевого пузыря.
- Проведение биопсии яичка. То есть проводится забор необходимого количества ткани, которая будет далее исследоваться на гистологии. Этим методом можно добиться того, что будет известно, нормально ли продуцируется сперма, то есть мужские половые клетки. Данная методика оправдывает себя, ее смело можно применять при подозрении у мужчины бесплодия.
- Анализ генетического генеза. Если выявлено у мужчины низкое количество сперматозоидов, то можно подозревать, что есть сбои генетического плана. Генетические исследования дают возможность решить данную проблему, и выяснить этиологию этого патологического состояния.
- Ультразвуковое исследование трансректального генеза. Этот метод исключает или подтверждает блокаду протока семявыносящего канала, в противном случае семенных пузырьков.
Неплохим дополнительным методом исследования мужчины на выявление или опровержения бесплодия является функциональная методика. То есть, как только произведено выделение спермы, лабораторно изучается длительность жизни мужских половых клеток. Таким образом, и этот момент можно выяснить и решить.

Лечебные мероприятия проводятся только тогда, когда полностью проведена диагностика мужского организма. В себя лечебное мероприятие включает следующие пункты:
- Оперативное лечение бесплодия. То есть проводятся всевозможные операции, чтобы добиться того, чтобы мужчина мог иметь свое потомство. Это может быть проведение операции на семявыносящем протоке, то есть исключение непроходимости. Проводится также вазэктомия, а также иные методики, которые индивидуальны для каждого больного.
- Купирование процессов инфекционного плана. Для этого назначаются средства антибактериального генеза, чтобы купировать процесс воспаления. Но не всегда вылеченный инфекционный процесс дает возможность мужчине иметь своего ребенка.
- Терапия гормонального происхождения.
- Решение вопроса сексуального плана. Прежде всего, необходимо решать проблему, если есть дисфункция эректильного плана.
- Проведение оплодотворения альтернативного плана. Существует множество способов проведения такой процедуры.
В первую очередь следует всегда помнить, что нельзя тянуть к визиту к врачу, если у вас уже несколько лет не получается зачать ребенка. Многие пациенты боятся идти к врачу, то есть впадают в панику. Этого делать не следует. В большинстве случаев вылечить пациента с вторичным бесплодием возможно. Для начала необходимо главную причину, чтобы ее же и устранить, если это конечно возможно. Придется длительное время проводить различные исследования и часто посещать, так как состояние является очень серьезной проблемой.
В первую очередь для любой женщины необходимо посетить гинеколога и пройти осмотр. Проводится это не сразу, сначала заранее на прием записываются, и доктор сам устанавливают дату приема пациента. Ведь необходимо проверять базальную температуру определенный промежуток времени каждый день, а также использовать тесты на момент овуляции. Данные результаты собирают воедино и доктору уже легче выстроить тактику дальнейшей диагностики или лечения.
Чтобы проверить проходимость и состоятельность труб матки проводится гистеросальпингография. А чтобы проверить состояние матки, то проводится гистероскопия. Если требуется удалить какую-либо причину в матке, например, кисту, то проводится лапароскопия. Удаляется интересующий элемент в матке. Если есть наличие спаек, то можно эти же способом их разъединить.

После вышеуказанных мероприятий, у женщины проверяется гормональный фон в организме. Перед тем, как сдавать данный анализ, женщина должна заранее подготовиться к нему. Пациентка не должна употреблять пищу и пить любую жидкость. Кроме этого, такой анализ сдается на 3 день цикла менструаций. Данное мероприятие направлено на то что, есть ли наличие высокого уровня мужских гормонов. Кроме того, определяется уровень:
- Фолликулостимулирующего гормона.
- Лютеинизирующего гормона.
- Пролактин.
- Эстрадиол.
- Прогестерон.
- Кортизол.
Что касается мужского обследования, то необходимо также проводить некоторые диагностические мероприятия. Проводится анализ выявления антител антиспермального генеза. При этом их не стоит пускать к яйцеклетке.
Также пациенту необходимо посетить некоторых врачей (андролог, уролог). Проводится ультразвуковое исследование, сдается сперма для проведения спермограммы. В индивидуальных случаях проводится MAR тест. После вышеуказанных диагностических мероприятий, лечащий врач назначает какое-либо необходимое лечение.
На сегодняшний день существует масса методик, чтобы помочь человеку. Ведь невозможность родить ребенка является для любого человека большой трагедией. Если по каким-либо причинам не удается помочь человеку, чтобы восстановить его репродуктивную функцию, существует альтернатива. Суррогатное материнство и экстракорпоральное оплодотворение является спасением для бесплодных пар.

Бесплодие: виды, причины, диагностика. К сожалению, уровень бесплодия на сегодняшний день достигает таких показателей, что о нем говорят чуть ли не все ведущие специалисты в области акушерства и гинекологии. Разнообразие форм, способствующих факторов этого заболевания, становиться с каждым годом намного больше, даже несмотря на высокий уровень оказания медицинской помощи населению. Именно поэтому врачи стараются привлечь внимание молодого поколения, которые только вступили в период репродуктивного возраста для того, чтобы максимально доступно донести о проблеме бесплодия и ознакомить со способами его предотвращения. Цифры, которые отражают уровень бесплодия во всем мире, не могут порадовать представителей медицинской сферы. Речь идет о 15-20% бесплодных пар, которые обречены на появление собственного ребенка в семье. Но, вот уже на протяжении нескольких десятков лет, даже с самой тяжелой формой бесплодия умело справляются современные альтернативные способы оплодотворения. Но перед тем, как выбрать один из методов репродуктивных технологий, необходимо четко установить причину заболевания и возможные способы разрешения этой проблемы с помощью консервативных методов лечения.
Виды бесплодия. По последним данным классификация форм бесплодия имеет широкую направленность. Так данную патологию классифицируют по некоторым признакам, среди которых особенно выделяют - формы бесплодия относительно пола, формы бесплодия относительно частоты возникновения, форма бесплодия относительно степени тяжести патологического процесса. Среди мировой практики репродуктивных клиник и других организаций, занимающихся медицинскими статистическими данными, бесплодие принято разделять на мужское, женское и сочетанное бесплодие. Частота случаев бесплодия среди женского населения составляет около 40-45 %, в то время как показатели мужского бесплодия варьируются в пределах 37-40%. На сочетанное или семейное бесплодие приходится около 15 % от всей численности населения.
Первичное бесплодие, данную категорию бесплодия рационально отнести к женской форме бесплодия, и вот почему: данный диагноз ставится на основании ряда причин, связанных с данными акушерского анамнеза. Первичное бесплодие ставится только в том случае, когда женщина на протяжении более одного календарного года не может забеременеть от своего партнера, при этом не используя различные контрацептивные средства. Помимо этого, основным критерием первичного бесплодия является отсутствие предыдущих беременностей и родов. Около 20 лет назад, согласно статистическим данным, первичное бесплодие встречалось, как минимум, в два раза чаще, нежели вторичное. На сегодняшний день ситуация приобрела несколько иной характер - для этого необходимо более подробно рассмотреть определение вторичного бесплодия.
Вторичное бесплодие-диагноз, который выставляется в случае отсутствия наступления беременности после того, как женщина хотя бы один раз была беременна. Как уже говорилось ранее, вторичное бесплодие встречалось гораздо реже, нежели первичное. Теперь положение изменилось, и частота вторичного бесплодия возросла за счет внедрения современных репродуктивных технологий. Такая процедура, как экстракорпоральное оплодотворение, способна решить проблему бесплодия на любом уровне сложности, однако, в качестве побочных эффектов ЭКО включает в себя предрасположенность к развитию осложнений со стороны работы женской половой системы, вплоть до вторичного бесплодия.
Причины бесплодия, лечение. Изучая по сей день различные скрытые факты о развитие того или иного заболевания, с которым врачам до сих пор не так-то просто справится (онкология, СПИД, генетические заболевания), этиология бесплодия вышла на новый уровень, и ведущие специалисты стараются изучать эту проблему разносторонне. Как выяснилось, причины возникновения бесплодия до конца не изучены, так, за последнее десятилетие была включена группа психологических факторов, которые способствуют возникновению трудностей оплодотворения.
Диагностика причины бесплодия не составляет труда, поскольку по последним данным, количество диагностических методов, которые активно применяются в репродуктивной сфере, насчитывает около 100 наименований начиная от простейших клинико-лабораторных исследований, которые использовались еще на этапе становления медицины, заканчивая сложными инструментальными диагностическими мероприятиями, которые дают возможность углубленно изучить свойства организма на молекулярном, генетическом и других уровнях. Количество необходимых исследований устанавливает лечащий врач супругов, а оснащенность оборудованием, для проведения различных диагностических мероприятий, находится на высшем уровне почти в каждом городе нашей страны. Ценовая политика диагностики бесплодия зависит прежде всего от степени тяжести и клинической формы бесплодия. Иногда супругам достаточно базового спектра исследований для того, чтобы установить истинную причину заболевания одного из супругов.
Причины бесплодия у женщин требуют особого внимания, поскольку в большинстве случаев причиной бесплодного брака являются именно проблемы женской половой системы. Ученые специалисты сгруппировали некоторые причины бесплодия у женщин для того, чтобы легче классифицировать форму патологии. Среди наиболее распространенных причин заболевания можно выделить следующие:

- Заболевания женской половой системы
- Эндокринные нарушения
- Травмы и хирургические вмешательства на органах женской половой системы
- Аутоиммунные заболевания
- Инфекционные заболевания (ВИЧ, СПИД, туберкулез)
- Врожденные аномалии развития органов малого таза, структур головного мозга
- Психические расстройства
Мужское бесплодие причины и лечение. В связи с тем, что уровень мужского бесплодия за последние годы значительно повысился, ведущие специалисты в области репродуктивного здоровья принялись за активное изучение этиологических факторов мужского бесплодия с новой точки зрения. При изучении проблемы учитывались некоторые социально-биологические аспекты жизни молодого поколения - уровень сексуального воспитания, средние показатели начала половой жизни юношей и т.д. Таким образом, полученные данные привели к следующим выводам - мужскому бесплодию зачастую способствуют:
- Воспалительные заболевания органов мужской половой системы
- Травмы и хирургические вмешательства на органах малого таза
- Венерические заболевания
- Инфекционные заболевания
- Врожденные аномалии развития органов мужской половой систем
- Незрелость структур головного мозга, отвечающих за регуляцию репродуктивной функции
- Генетические аномалии
- Обменные нарушения
- Тяжелые соматические заболевания
Врач, лечащий мужское бесплодие, называется врач- андролог. Несмотря на то, что врач репродуктолог имеет возможность решить проблему как мужского, так и женского бесплодия, его территориальная доступность достаточно ограниченная. К тому же, как показывает статистика, мужчины, в случае подозрений на какие-либо отклонения в мужской половой системе, чаще всего обращаются к врачу- урологу, или врачу- хирургу. Деятельность врача-андролога заключается в своевременном выявлении патологии мужской половой системы, связанной с нарушениями образования спермы, ее выделением и другими патологическими состояниями.
Диагностика бесплодия в классическом представлении заключается в нескольких этапах. Обследование пациентов с подозрением на бесплодие должно проходить в определенном порядке. В случае возникновения проблем с зачатием малыша обследованию подлежат оба супруга, даже при наличии прямых показаний для женского или мужского бесплодия. Вторым, не менее важным, условием диагностики бесплодия является структура обследования пациентов. Зачастую, врачи используют классическую схему обследования гинекологического/ урологического больного, добавляя лишь современные диагностические мероприятия в схему обследования, чтобы ускорить процесс клинических мероприятий и установить истинную причину бесплодия. Согласно медицинским источникам, классическая схема исследования заключается в следующих этапах:
- Сбор анамнеза (осмотр, опрос, и т.д.)
- Клинико-лабораторные исследования (анализы крови, мочи, посевы и т.д.)
- Дополнительные инструментальные исследования (УЗИ, МРТ, рентгенографическое исследование, лапароскопия и т.п.)

Диагностика и лечение бесплодия
Женское бесплодие: диагностика. Специфика обследования женского организма заключается в изучении функции гормонального регулирования женской половой системы, в частности регуляции менструального цикла. К тому же, с учетом особенности строения системы нейрогуморальной регуляции, специалисты делают упор на исследование желез внутренней секреции, которые входят в состав не только женской половой системы, но и эндокринную систему, в частности. На стабильность работы этих структур влияет, как и данные анамнеза (наличие абортов, внематочных беременностей, выкидышей и т.д.), так и сопутствующие заболевания, причем немаловажным являются данные о наследственности со стороны родственников женщины.
Лапароскопия при бесплодии - применяется достаточно часто, поскольку это хирургическое вмешательство имеет несколько положительных качеств. В первую очередь, это современное оперативное вмешательство дает возможность извлечь необходимый участок и патологическое новообразование из органов малого таза для его тщательного обследования. Во-вторых, устранение того самого патологического очага может автоматически решить проблему бесплодия. При этом, лапароскопический метод активно используется в любых хирургических направлениях, поскольку его показатели минимальной травматизации органов и высокого уровня скорейшего физического восстановления поражают многих специалистов.
Бесплодие у мужчин: диагностика.
Мужское бесплодие, азооспермия: анализ спермограммы. Обследование мужской половины населения направлено на изучение структуры сперматозоидов, их количества, подвижности и других не менее важных свойств. Для этого, в медицине используют микроскопический метод исследования - метод диагностики, основанный на исследовании биологического материала под многократным увеличением, которое обеспечивает микроскоп. Диагноз азооспермия является прямым показанием к постановке диагноза - бесплодие. Эта патология включает в себя следующие особенности: при исследовании генетического материала (спермы), в поле зрения микроскопа находится менее 3 спермиев, иногда - полностью отсутствуют.
Тест на мужское бесплодие. Последнее нововведение в области функциональных исследований, позволило в кратчайшие сроки установить наличие различных форм нарушений спермообразования, без каких-либо дополнительных инструментальных исследований. Эти тесты, схожи по принципу тестов на овуляцию или тестов на беременность - они определяют наличие подвижных сперматозоидов в эякуляте мужчины.
Обследование пары на бесплодие. Пройти в плановом порядке комплексное обследование супружеской пары можно на базе государственных и частных медицинских учреждений. Как показывает практика, наиболее обширным спектром диагностических манипуляций, необходимой аппаратурой обладают именно коммерческие клиники. Не так давно, на территории нашего государства были введены специализированные центры репродуктивного здоровья, которые оказывают квалифицированную помощь, касательно проблем с естественным зачатием ребенка любой сложности.
Определить благоприятность условий внутренней среды, то есть полости матки, для сперматозоидов, можно посткоитальным тестом. Проба шуварского основана на предыдущем исследовании, однако при таких условиях: изучение цервикальной слизи происходит после полового акта партнеров в период овуляции (12-14 день). Тогда, после короткого промежутка между половым актом (не позднее 6 часов после его окончания), специалисты наблюдают динамику сперматозоидов, а также их количественное присутствие. Результаты исследования классифицируются в зависимости от оставшихся в поле зрения сперматозоидов.
hla совместимость супругов и пробы на совместимость крови. Это клинико-лабораторное исследование основано на изучении генетической совместимости супругов. Благодаря сложнейшей технологии цепной полимеразной реакции, еще на этапе диагностики есть возможность определить несовместимость партнеров, в случае бесплодия неясной этиологии, а также установить противопоказания к планированию беременности в ходе прегравидарной подготовки супругов.